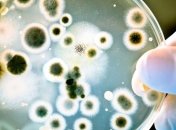
Итальянские ученые нашли изьян в "непобедимой" бактерии

Новости по теме Бактерии
-

Россияне нашли в украинском мясе кишечную палочку, сальмонеллы и листерии.
-

Гомеопатические средства влияют не только на бактерии, но и на вирусы.
-

Шанхайские ученые заключили, что причиной ожирения может быть бактериальная инфекция.
-

Ученые из голландского Дельтфского технического университета приступили к полевым испытаниям самовосстанавливающегося бетона.
-
Итальянские ученые обнаружили "ахиллесову пяту" 1-й из самых устойчивых к антибиотикам бактерий.
-

Во рту среднестатистического человека содержатся миллиарды бактерий.
-

Ученые обнаружили бактерию, способную выдержать сильную токсичность и произвести 24-каратное золото.
-

Диабет могут провоцировать организмы, живущие в желудочно-кишечном тракте, считают датские исследователи из Копенгагенского университета.
-

Ученые установили, что микроорганизмы сбиваются в популяции и ведут друг против друга "войны" при помощи антибиотиков.
-

Опубликован отчет Европейского центра по контролю и профилактике заболеваний.




